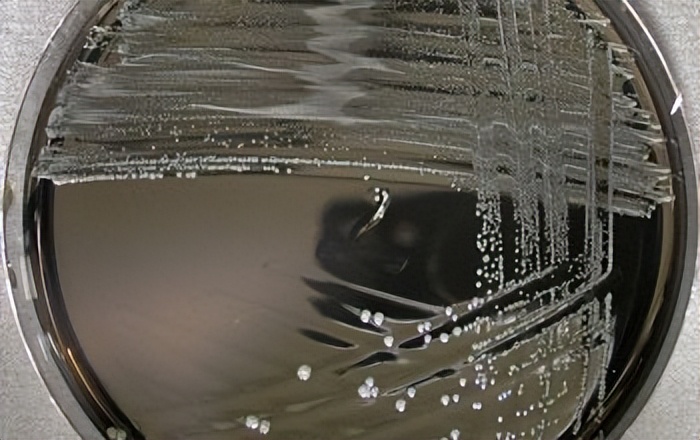
拟杆菌属重要菌种——Bacteroidesuniformis，控制好其稳态很重要

拟杆菌是革兰氏阴性、专性厌氧菌,在人类肠道微生物群中含量丰富,构成了肠道菌群中大部分比例。
Bacteroides uniformis (一般简称为 B.uniformis),翻译为单形拟杆菌或普通拟杆菌,是拟杆菌属的主要成员,在肠道中起着重要的作用。也被鉴定为阴道微生物组的组成部分。
Bacteroides uniformis是与人类粪便中异黄酮染料木黄酮降解相关的特定细菌物种,可以产生纤维素酶和淀粉酶,降解复杂多糖。
Bacteroides uniformis与肠炎、厌食、肥胖、糖尿病、腹胀、认知发育与情绪运动、多动症、慢性肾病、骨质疏松等相关,是可引起人类或动物疾病的物种,不太可能在人群中传播,并且存在足够的预防或治疗方法。
对单形拟杆菌进行深入研究,有助于我们更好地理解其在人体肠道中的功能,并为相关疾病的预防和治疗提供新的思路。
01
认识单形拟杆菌 Bacteroides uniformis
Bacteroides uniformis是一种革兰阴性细菌,呈杆状。它们通常具有弯曲或弯钩形态,并且没有芽胞。
图源:Microbe Canvas
生理特性
Bacteroides uniformis是一种厌氧菌,不能在氧气存在的环境中生长。它们通常能够利用多糖类物质作为碳源,如淀粉、纤维素和其他复杂碳水化合物。还可以产生一些酶,如纤维素酶和淀粉酶,用于降解消化这些复杂碳水化合物。
分布和生存环境
Bacteroides uniformis 是人体 肠道 , 阴道 中 常见的细菌 之一,也可以在 其他动物 的肠道中找到。它们在肠道中扮演重要的生态角色,参与 食物消化、营养吸收和免疫调节 等过程。 Bacteroides uniformis 能够适应肠道的微生态环境,与其他肠道细菌相互作用。
功能和代谢
Bacteroides uniformis在肠道中具有多种功能和代谢活性。它们参与葡萄糖和其他碳水化合物的代谢,并产生短链脂肪酸(如丙酸和乙酸),这些酸有益于肠道健康。此外,Bacteroides uniformis还参与胆固醇代谢、氨基酸代谢和维生素合成等生物化学过程。
02
Bacteroides uniformis ——减肥菌群-肥胖
肥胖和肥胖相关疾病构成了世界范围内的重大公共卫生问题。除了传统的*肥药减**物外,下一代益生菌(NGP)似乎非常有希望作为潜在的肥胖预防和治疗药物。
主要的候选NGP已在肥胖和肥胖相关疾病的临床前模型中显示出前景,例如:
- Akkermansia muciniphila
- Faecalibacter prausnitzii
- Anaerobutyricum Hallii
- Bacteroides uniformis
- Bacteroides coprocola
- Parabacteroides distasonis
- Parabacteroides goldsteinii
- Hafnia alvei
- Odoribacter Laneus
- Christensenella minuta
B.uniformis 已被证明具有对抗肥胖和代谢紊乱的有益特性。在动物模型中, B. uniformis与减肥、降低血清胆固醇和甘油三酯水平以及改善肝脂肪变性有关。此外,它还与血清瘦素水平降低、空腹血糖浓度降低和糖耐量改善有关。
推测的机制包括调节肠道菌群和改善肠道菌群失调、改善肠道屏障功能、减少慢性低度炎症和调节肠道肽分泌。
一项对41名体重指数(BMI)正常的个体肠道菌群和内脏脂肪面积 (VFA)的研究显示,内脏脂肪面积高/低(VFA)两组的肠道菌群存在显著差异,在 L-VFA 组中,B. plebeius 和B.uniformis含量很高。此外,B.uniformis与血清 LDL-胆固醇水平呈负相关。
另一项对32名肥胖成年人(14 名接受了腹腔镜袖状胃切除术 (LSG))和30名基线健康对照者的肠道菌群以及身体指标的研究,并在术后 6 个月进行了随访。通过磁共振成像测量腹部内脏脂肪面积(VFA)和皮下脂肪面积(SFA)。腰围、臀围、腰臀比(WHR)和体重指数(BMI)被列为简单的肥胖参数。通过宏基因组测序分析肠道微生物组。在与腹部内脏脂肪面积(VFA)负相关的物种中,Eubacteria eligens相关性最强,其次是Clostridium citroniae、C. symbiosum、 Bacteroides Uniformis 、E. ventriosum、C. hathewayi等。
一项涉及 45 名儿童(6 至 12 岁)的横断面研究调查了肠道微生物群与儿童肥胖之间的关系。发现两个BMI组之间的多样性存在差异。这种差异包括真杆菌属(Eubacterium)、普拉梭菌(Faecalibacterium prausnitzii)、Dialister、Monoglobus pectinilyticus、Bifidobacterium pseudocatenulatum、Intestinibacter bartlettii、 Bacteroides intestinalis、 Bacteroides uniformis (单形拟杆菌)和 史密斯甲烷杆菌(Methanobrevibacter smithii)。
一项针对减肥手术是否显著改善体重的研究显示单形拟杆菌的丰度可能影响手术后的效果。
术前属于拟杆菌门和厚壁菌门的成员丰度存在差异无应答组:
富含拟杆菌科、拟杆菌属、单形拟杆菌、Alistipes Finegoldii、Alistipes alistipes、Dorea formicigenerans 、瘤胃球菌。
应答组:
富含消化链球菌科、 Gemmiger、Gemiger formicilis、Barnesiella、Prevotellaceae 、 Prevotella。
线性判别分析 >2;p < 0.05。与有反应组相比,无反应组中普氏菌与拟杆菌的比率显着较低 (p = 0.048)。
03
Bacteroides uniformis ——神经厌食症
神经性厌食症(Anorexia nervosa, AN)的特点是一种神秘的食物回避模式,导致严重的营养不良,这种疾病在青春期早期发展。近期,在《Nature Microbiology》上发表的文章研究了77名患有神经性厌食症的成年女性和70名被认为是健康体重的对照组。
利用宏基因组学,作者对微生物组的细菌和病毒成分进行了深入分析。细菌基因组中的结构变异,特别是 Bacteroides uniformis (单形拟杆菌)中的结构变异,可能造成了硫胺素生产的破坏。
硫胺素(或称维生素B1)缺乏会影响人体健康,包括记忆丧失、焦虑、抑郁、易怒、失眠、食欲减退和胃肠道不适。这也可以解释在神经性厌食症患者中普遍观察到的硫胺素缺乏的现象。
04
Bacteroides uniformis ——
对认知发育与情绪运动很重要
认知发展
一项针对健康以色列阿拉伯儿童的横断面研究显示一些菌群分类学差异与儿童智商测试FSIQ评分显着正相关,包括Prevotella(普雷沃氏菌属)、Dialister属、Sutterella(萨特氏菌属)、Ruminococcus callidus和 Bacteroides uniformis (单形拟杆菌)。
情绪相关
一项针对长期封闭环境中心理变化和肠道菌群的研究,鉴定出四种潜在的“精神抗生素”(单形拟杆菌 Bacteroides Uniformis、Roseburia inulinivorans、Faecalibacter prausnitzii、Eubacterectale )。
根据宏基因组、宏蛋白质组和代谢组学分析,四种潜在的精神抗生素主要通过与神经系统功能相关的三种途径改善情绪:
首先,通过发酵膳食纤维,它们可能产生短链脂肪酸,例如丁酸和丙酸;
其次,它们可能调节天冬氨酸、谷氨酸、色氨酸等氨基酸代谢途径(例如,将谷氨酸转化为γ-氨基丁酸;将色氨酸转化为血清素、犬尿酸或色胺);
第三,它们可能调节其他途径,例如牛磺酸和皮质醇代谢。此外,动物实验的结果证实了这些潜在的精神抗生素对情绪的积极调节作用和机制。
运动相关
肠道微生物群可能有助于改善运动表现。日本庆应义塾大学先进生命科学研究所通过分析25名男性长跑运动员的比赛成绩后发现,运动员粪便中单形拟杆菌( Bacteroides uniformis )的丰度与其3000米比赛成绩间存在相关性。
在随后的一项随机、双盲、安慰剂对照研究中,研究人员让健康男性志愿者服用α-环糊精,以增加肠道中的单形拟杆菌总量。结果表明,补充α-环糊精可以提高人体的耐力运动能力。
此外,在小鼠实验中,食用单形拟杆菌显著延长了动物游泳的持续时间;动物盲肠短链脂肪酸浓度以及肝脏中与糖异生相关酶的基因表达均上升,肝糖原含量降低。该研究表明,单形拟杆菌可能通过促进肝脏内源性葡萄糖生成,增强个体的耐力运动能力。
05
Bacteroides uniformis——
多项研究显示在多项糖尿病患者丰度降低
妊娠糖尿病
妊娠合并糖尿病包括孕前糖尿病(PGDM)和妊娠期糖尿病(GDM)。 一项针对234份孕妇粪便样本的16S rRNA测序数据显示,随着妊娠的进展,妊娠糖尿病PGDM 组的肠道细菌种类数量有所减少。巨单胞菌、拟杆菌和 Roseburia Enteris 在 PGDM 组中富集,而 Bacteroides vulgatus、Faecalibacter prausnitzii、Eubacterectale、 Bacteroides uniformis (单形拟杆菌)、Eubacteria eligens、Subdolilegum 在对照组中比例更高,这些菌血糖与血糖特征呈负相关。
二型糖尿病
一项针对亚洲人的包括36个不同二型糖尿病T2DM研究(健康,n = 3378;T2DM,n = 551)的meta分析显示,T2DM 组中普通杆菌菌、单形拟杆菌和普氏粪杆菌较低。
另一项包括29名T2DM患者和28名健康对照者研究显示,Megamonas funiformis 和 Escherichia 的丰度在T2DM患者的肠道中显着增加。相反,Bacteroides stercoris、单形拟杆菌和Phascolarctobacterium faecium的丰度降低。
06
Bacteroides uniformis ——改善肠炎
单形拟杆菌 ( Bacteroides uniformis ) 还可能调节动物肠道稳态,减轻小鼠结肠炎。一项研究使用B.uninis JCM5828 及其代谢物对患有葡聚糖硫酸钠盐 (DSS) 诱导的结肠炎的雌性 C57BL/6J小鼠进行治疗。
Bacteroides uniformis治疗显著减轻了结肠炎的进展并恢复了机械和免疫屏障蛋白的表达。此外,Bacteroides uniformis还增加了共生菌双歧杆菌和阴道乳杆菌的丰度,同时减少了致病性埃希氏菌、志贺氏菌的丰度,并调节了肠道胆汁酸代谢。
Bacteroides uniformis在很大程度上调节结肠组织中NF-κB和丝裂原激活蛋白激酶(MAPK)信号通路关键调节蛋白的表达以及TH17细胞的分化。然而,Bacteroides uniformis在体外不能直接抑制TH17细胞分化;它应该是通过参与胆汁酸代谢和调节关键代谢物(α-鼠胆酸、猪去氧胆酸和异石胆酸)来调节固有层的过程,从而调节肠道免疫反应。
此外在一项溃疡性结肠炎(UC)患者的菌群研究中,六种拟杆菌属表现出显着较低的相对丰度,十二种拟杆菌属被发现与至少一项疾病活动指标显着相关。五个物种( Alistipes putredinis、Bacteroides stercoris、Bacteroides Uniformis、Bacteroides rodentium、Parabacteroides merdae )的相对丰度与溃疡性结肠炎活性的四个指标中的三个相关。
12 个关键物种表达了与 UC 发病机制相关的5 个基因(TARP、C10ORF54、ITGAE、TNFSF9和LCN2 )。作为潜在生物标志物的关键物种的丧失可能会加剧 UC 活动。
比较功能性腹胀和膨胀(FABD)患者和12健康个体粪便微生物群的多样性和组成,并评估小肠细菌过度生长 (SIBO) 。结果显示FABD 组的微生物多样性显着低于对照组。与健康对照相比,FABD 患者中变形菌的比例显着升高,放线菌的比例显着降低。与健康对照相比,FABD患者中粪杆菌的比例显着升高,而SIBO(+)FABD患者中普氏菌和粪杆菌的比例也显着升高。与健康对照相比,FABD 患者的普氏粪杆菌 (Faecalibacter prausnitzii) 的丰度显着增加,但单形拟杆菌 ( Bacteroides uniformis )和青春双歧杆菌数量明显减少。
乳糜泻患者肠道中的 Bacteroides distasonis、Bacteroides fragilis / Bacteroides thetaiotaomicron、Bacteroides Uniformis、Bacteroides ovatus比对照组更少(p<0.05)。
07
Bacteroides uniformis
——关节骨骼类疾病患者中下降
骨质疏松
一项研究中,与对照组相比,几个物种的丰度发生了变化,在骨质疏松组中发现了特定的功能途径,骨质疏松组中下列菌群的水平下降:
- 阿克曼氏菌(Akkermansia muciniphila)
- 埃格特氏菌(Bacteroides eggerthii)
- 脆弱拟杆菌(Bacteroides fragilis)
- 单形拟杆菌( Bacteroides uniformis )
- Butyricimonas synergistic
类风湿性关节炎
一项研究包括 76 名类风湿关节炎患者的粪便宏基因组和血浆代谢组的分期概况。
- Bacteroides uniformis 和 Bacteroides plebeius 的耗竭削弱了糖胺聚糖代谢(p<0.001),在四个阶段持续损伤关节软骨。
- 大肠杆菌的升高增强了II期和III期的精氨酸琥珀酰转移酶途径(p<0.001),这与类风湿因子的增加有关(p=1.35×10-3),并可能导致骨丢失。
- 异常高水平的甲氧基乙酸(p=1.28×10–8)和半胱氨酸-S-硫酸盐(p=4.66×10–12)分别在II期抑制成骨细胞和在III期增强破骨细胞,促进骨侵蚀。
- 在第四阶段,肠道通透性的持续增加可能会诱导肠道微生物侵入关节滑液。
骨关节炎
骨关节炎是一种病因不明的慢性退行性疾病。一项研究针对骨关节炎患者(n = 32)和正常对照组(n = 57)肠道菌群检测,宏基因组测序显示,骨关节炎患者中Bacteroides stercoris、Bacteroides vulgatus、Bacteroides uniformis 在物种水平上的丰度显著降低,大肠杆菌、肺炎克雷伯菌、Shigella flexneri、唾液链球菌在骨关节炎中显著增加。
08
Bacteroides uniformis ——
过高也可能与其他多项疾病有关
特应性皮炎AD
使用 16S rRNA 测序分析了 93 名志愿者的粪便样本,其中包括 44 名 AD 患者和 49 名健康对照受试者,年龄为 6-22 岁。
卟啉单胞菌科、Blautia、Parabacteroides、Bacteroides ovatus、Bacteroides uniformis 和 Prevotella stercorea 的相对丰度显著较高(P < 0. 05) AD 患者高于健康对照者。与 AD 患者相比,健康对照受试者中梭状芽胞杆菌和粪疟原虫含量较高 (P < 0.05)。
儿童多动症
对11项儿童多动症研究的meta分析显示,拟杆菌属与多动和冲动水平相关。在物种水平上,多动症儿童 Faecalibacterium 丰度较低,但 Bacteroides uniformis、肠球菌、双歧杆菌和 Odoribacter 增加,可能导致中枢神经系统多巴胺相关功能受损。
此外,多动症儿童肠道中Faecalibacterium丰度的降低可能导致炎症细胞因子的渗透性和交叉性更高。
一项调查多动症儿童及其饮食模式和肠道菌群的研究显示,在注意缺多动障碍(ADHD)组中,粪肠拟杆菌(B. coprocola)的相对丰度降低,而单形拟杆菌(B.uniformis)、卵形拟杆菌(B.ovatus)和粪类杆菌(S. stercoricanis)的相对丰度升高。
结直肠癌转移组
转移性结直肠癌组和非转移性结直肠癌组患者的肠道菌群存在差异。在属水平上,拟杆菌属菌种脆弱拟杆菌和单形拟杆菌组成在转移组中显着高于非转移组。
PD-1免疫疗法反应
肠道微生物群被认为是调节免疫检查点*制剂抑**治疗功效的关键因素。一项波兰黑色素瘤患者队列中PD-1疗法反应与基线肠道微生物组的研究显示,普氏菌和单形拟杆菌的丰度与反应有关,而无反应者的肠道微生物群富含普氏粪杆菌和脱硫弧菌以及一些未分类的厚壁菌门。
慢性肾病
一项台湾地区人群肠道菌群研究显示,在慢性肾病 (CKD)患者中发现的最丰富的属是拟杆菌属,在物种水平上,血液透析患者中的B. ovatus、B. caccae 、 B.uniformis表现出显著丰度,而腹膜透析患者中的Blautia表现出较高的丰度。
白塞病
在活动性白塞病BD患者其单形拟杆菌丰度显著高于其匹配的健康对照和处于非活动状态的疾病患者 ( p = 0.038)。
09
Bacteroides uniformis ——代谢和调节
单形拟杆菌可以消化多种膳食纤维,作为一种代谢膳食纤维产生乙酸的肠道菌已有大量研究表明日常膳食纤维摄入会影响单形拟杆菌的丰度。
一项横断面研究中检查了全谷物和精制谷物、纤维和麸质的习惯摄入是否与肠道微生物群相关。对779 名参与者137 项食物频率的调查问卷和肠道菌群的分析显示。最高全谷物摄入量四分位与较高丰度的普通拟杆菌、普氏粪杆菌、Blautiaproducta和Rikenellaceae以及较低丰度的单形拟杆菌有关。
一项对不同特异性(低-低聚果糖、低至中-2 型抗性淀粉、中-果胶和高-不溶性 β-1,3-葡聚糖特异性)纤维的微生物发酵研究显示,高特异性不溶性β-葡聚糖促进目标细菌大量增加, Anaerostipes sp. 平均从0.3%增加到16.5%,单形拟杆菌平均为 2.5% 至 17.9%,这与这些细菌所在的每个微生物群落中相关代谢物(分别为丁酸盐和丙酸盐)比例的增加有关。
水溶性醋酸纤维素 (WSCA) 是一种合成纤维来源,可以导致拟杆菌属成员的丰度增加,尤其是单形拟杆菌。在四种具有代表性的人类肠道拟杆菌属中,只有单形拟杆菌在WSCA上的纯培养物中生长并活跃地产生乙酸。
一项对健康志愿者进行了为期 4周的营养干预分析天然单宁提取物混合物对肠道微生物变化的研究显示。从前两周起就可以观察到微生物群的组成和功能的变化,测序显示以下菌相对丰度增加,例如:
- 单形拟杆菌
- Ruminococcus bicirculans
- Faecalibacterium prausnitzii
- Lachnospiraceae
利用同位素标记发,发现食用菊粉富集的前三种细菌为单形拟杆菌( Bacteroides uniformis )、产酸拟杆菌(Bacteroides acidifaciens)和狄氏副拟杆菌(Parabacteroides distasonis)。
一项研究评估富含黄酮类化合物的蔓越莓多酚(CP)和龙舌兰(AG)(一种高支链龙舌兰衍生的新果聚糖)对C57BL6雄性小鼠的心脏代谢反应、肠道微生物群组成、代谢内毒素血症和粘膜免疫调节的影响,该雄性小鼠喂食致肥胖高脂肪高糖(HFHS)饮食9周。AG,单独或与CP(CP+AG)联合,主要刺激聚糖降解细菌:
- Muribaculum intestinale
- Faecalibaculum rodentium
- Bacteroides uniformis
- Bacteroides acidifaciens
与未经治疗的小鼠相比,接受AG的肥胖小鼠中聚糖降解细菌的增加与丁酸水平的显著增加一致。
总的来说,研究发现高特异性不溶性β-葡聚糖、天然单宁提取物混合物、菊粉、蔓越莓多酚和龙舌兰能增加 Bacteroides uniformis的丰度。
主要参考文献:
Vallianou NG, Kounatidis D, Tsilingiris D, Panagopoulos F, Christodoulatos GS, Evangelopoulos A, Karampela I, Dalamaga M. The Role of Next-Generation Probiotics in Obesity and Obesity-Associated Disorders: Current Knowledge and Future Perspectives. Int J Mol Sci. 2023 Apr 4;24(7):6755.
Nie X, Chen J, Ma X, Ni Y, Shen Y, Yu H, Panagiotou G, Bao Y. A metagenome-wide association study of gut microbiome and visceral fat accumulation. Comput Struct Biotechnol J. 2020 Sep 20;18:2596-2609.
Murga-Garrido SM, Ulloa-Pérez EJ, Díaz-Benítez CE, Orbe-Orihuela YC, Cornejo-Granados F, Ochoa-Leyva A, Sanchez-Flores A, Cruz M, Castañeda-Márquez AC, Plett-Torres T, Burguete García AI, Lagunas-Martínez A. Virulence Factors of the Gut Microbiome Are Associated with BMI and Metabolic Blood Parameters in Children with Obesity. Microbiol Spectr. 2023 Feb 14;11(2):e0338222.
Lapidot Y, Maya M, Reshef L, Cohen D, Ornoy A, Gophna U, Muhsen K. Relationships of the gut microbiome with cognitive development among healthy school-age children. Front Pediatr. 2023 May 19;11:1198792.
Cheng M, Zhao Y, Cui Y, Zhong C, Zha Y, Li S, Cao G, Li M, Zhang L, Ning K, Han J. Stage-specific roles of microbial dysbiosis and metabolic disorders in rheumatoid arthritis. Ann Rheum Dis. 2022 Aug 19;81(12):1669–77.
Shirvani-Rad S, Ejtahed HS, Ettehad Marvasti F, Taghavi M, Sharifi F, Arzaghi SM, Larijani B. The Role of Gut Microbiota-Brain Axis in Pathophysiology of ADHD: A Systematic Review. J Atten Disord. 2022 Nov;26(13):1698-1710.
Wang LJ, Yang CY, Chou WJ, Lee MJ, Chou MC, Kuo HC, Yeh YM, Lee SY, Huang LH, Li SC. Gut microbiota and dietary patterns in children with attention-deficit/hyperactivity disorder. Eur Child Adolesc Psychiatry. 2020 Mar;29(3):287-297.
Hao Z, Meng C, Li L, Feng S, Zhu Y, Yang J, Han L, Sun L, Lv W, Figeys D, Liu H. Positive mood-related gut microbiota in a long-term closed environment: a multiomics study based on the "Lunar Palace 365" experiment. Microbiome. 2023 Apr 24;11(1):88.
Ren Y, Hao L, Liu J, Wang P, Ding Q, Chen C, Song Y. Alterations in the Gut Microbiota in Pregnant Women with Pregestational Type 2 Diabetes Mellitus. mSystems. 2023 Apr 27;8(2):e0114622.
Wu X, Park S. Fecal Bacterial Community and Metagenome Function in Asians with Type 2 Diabetes, According to Enterotypes. Biomedicines. 2022 Nov 21;10(11):2998.
Lv M, Li L, Li W, Yang F, Hu Q, Xiong D. Mechanism research on the interaction regulation of Escherichia and IFN-γ for the occurrence of T2DM. Ann Palliat Med. 2021 Oct;10(10):10391-10400.
Yan Y, Lei Y, Qu Y, Fan Z, Zhang T, Xu Y, Du Q, Brugger D, Chen Y, Zhang K, Zhang E. Bacteroides uniformis-induced perturbations in colonic microbiota and bile acid levels inhibit TH17 differentiation and ameliorate colitis developments. NPJ Biofilms Microbiomes. 2023 Aug 14;9(1):56.
Nomura K, Ishikawa D, Okahara K, Ito S, Haga K, Takahashi M, Arakawa A, Shibuya T, Osada T, Kuwahara-Arai K, Kirikae T, Nagahara A. Bacteroidetes Species Are Correlated with Disease Activity in Ulcerative Colitis. J Clin Med. 2021 Apr 17;10(8):1749.
Noh CK, Lee KJ. Fecal Microbiota Alterations and Small Intestinal Bacterial Overgrowth in Functional Abdominal Bloating/Distention. J Neurogastroenterol Motil. 2020 Sep 30;26(4):539-549.
Wang H, Zhang K, Wu L, Qin Q, He Y. Prediction of Pathogenic Factors in Dysbiotic Gut Microbiomes of Colorectal Cancer Patients Using Reverse Microbiomics. Front Oncol. 2022 Apr 27;12:882874.
Ye S, Yan F, Wang H, Mo X, Liu J, Zhang Y, Li H, Chen D. Diversity analysis of gut microbiota between healthy controls and those with atopic dermatitis in a Chinese population. J Dermatol. 2021 Feb;48(2):158-167.
Zhou P, Dai Z, Xie Y, Li T, Xu Z, Huang Y, Sun D, Zhou Y. Differences in tissue-associated bacteria between metastatic and non-metastatic colorectal cancer. Front Microbiol. 2023 Jun 9;14:1133607.
Shivani S, Kao CY, Chattopadhyay A, Chen JW, Lai LC, Lin WH, Lu TP, Huang IH, Tsai MH, Teng CH, Wu JJ, Hsieh YH, Wang MC, Chuang EY. Uremic Toxin-Producing Bacteroides Species Prevail in the Gut Microbiota of Taiwanese CKD Patients: An Analysis Using the New Taiwan Microbiome Baseline. Front Cell Infect Microbiol. 2022 Apr 26;12:726256.
Kim JC, Park MJ, Park S, Lee ES. Alteration of the Fecal but Not Salivary Microbiome in Patients with Behçet's Disease According to Disease Activity Shift. Microorganisms. 2021 Jul 6;9(7):1449.
Um CY, Peters BA, Choi HS, Oberstein P, Beggs DB, Usyk M, Wu F, Hayes RB, Gapstur SM, McCullough ML, Ahn J. Grain, Gluten, and Dietary Fiber Intake Influence Gut Microbial Diversity: Data from the Food and Microbiome Longitudinal Investigation. Cancer Res Commun. 2023 Jan 11;3(1):43-53.
Cantu-Jungles TM, Bulut N, Chambry E, Ruthes A, Iacomini M, Keshavarzian A, Johnson TA, Hamaker BR. Dietary Fiber Hierarchical Specificity: the Missing Link for Predictable and Strong Shifts in Gut Bacterial Communities. mBio. 2021 Jun 29;12(3):e0102821.
Molino S, Lerma-Aguilera A, Jiménez-Hernández N, Rufián Henares JÁ, Francino MP. Evaluation of the Effects of a Short Supplementation With Tannins on the Gut Microbiota of Healthy Subjects. Front Microbiol. 2022 Apr 27;13:848611.